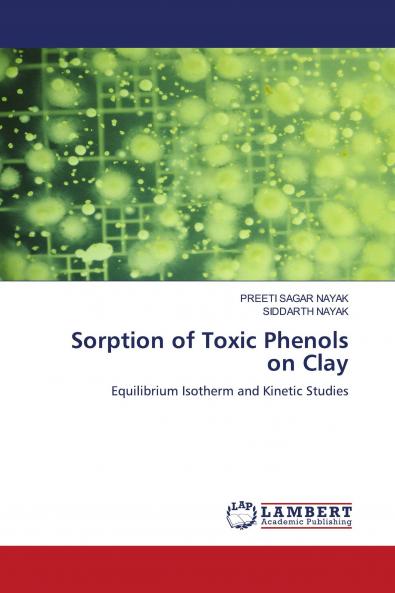
Sorption of Toxic Phenols on Clay

English
Paperback
₹7150
(All inclusive*)
Delivery Options
Please enter pincode to check delivery time.
*COD & Shipping Charges may apply on certain items.
Review final details at checkout.
Looking to place a bulk order? SUBMIT DETAILS
About The Book
Description
Author
The range of topics addressed in this publication is considerable from phenols and nitro substituted toxic phenols to low cost clay. The study examines the effectiveness of nearly inexpensive sorbent clay in removing phenols from wastewater by sorption. The influences of various factors such as particle size pH concentration and temperature on the sorption capacity have been studied. This study showed that clay could be used as an efficient sorbent material for the sorption of phenols from aqueous solutions. Langmuir isotherm and Kinetics adsorption constants were calculated and it is seen that the sorption data for phenols onto clay fitted well in this model. The study is important for designing batch reactor treatment plant for phenolic effluents where continuous removal can be achieved on a large scale. This publication represents an advanced textbook for graduate students and as well as offering to research workers who are working in the field of adsorption. The publication will appeal to workers researchers and will act as a vital resource for chemists environmentalists sorption scientists post-graduate students doctoral and post-doctoral fellows.
Delivery Options
Please enter pincode to check delivery time.
*COD & Shipping Charges may apply on certain items.
Review final details at checkout.
Details
ISBN 13
9783843369381
Publication Date
-21-11-2010
Pages
-188
Weight
-263 grams
Dimensions
-150x220x10.26 mm